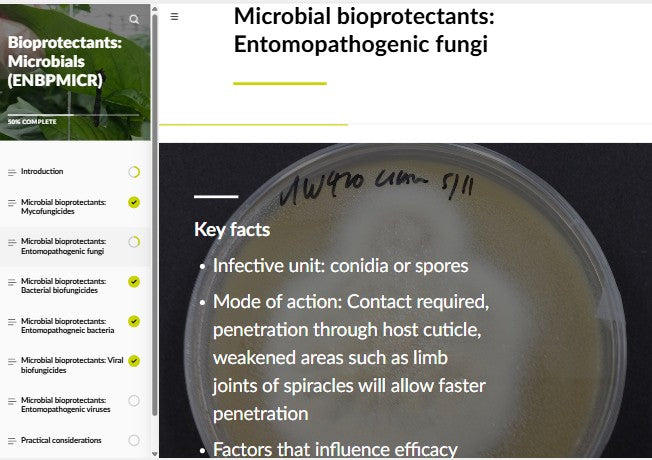

Bioprotectants: Microbials (BPMAEN0923)
Discover how microbial bioprotectants are reshaping pest and disease management in modern agriculture. This course explores the use of bacteria, fungi, and viruses—including the well-known Bacillus thuringiensis—to provide targeted, sustainable pest control.
You’ll learn how these organisms act through antibiosis, parasitism, and competition, and how factors like environmental conditions and application timing influence their success.
Designed for agronomists and IPM advisors, this course offers practical insights into integrating microbial tools into effective, eco-friendly crop protection strategies.
- Difficulty: Advanced
Couldn't load pickup availability
By completing/passing this course, you will attain the certificate Academy general certificate